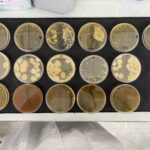

May 2023 Issue
A Greasy Player in Alzheimer’s Disease
Our study using transgenic mice and advanced molecular approach has revealed that cholesterol directly links to the origin of Alz-heimer’s disease.
Posted by John Lee on Tuesday, May 30th, 2023 in May 2023, Alzheimer’s Disease, Amyloid Precursor Protein, Cholesterol
Relationship between Childhood Media Use and Participation and Interest in Extracurricular Activities in Adolescence
This study examines how media exposure during childhood might influence the activities adolescents partake in and enjoy.
Posted by John Lee on Tuesday, May 30th, 2023 in May 2023, Adolescence, Childhood, Extracurricular Activities, Media
Purifying Chlamydomonas Reinhardtii Axonemes to Study Microtubule Bundles
Axonemes were purified from Chlamydomonas Reinhardtii alga cells and used to grow multiple microtubule extensions to then be bundled, to study microtubule bundles.
Posted by John Lee on Tuesday, May 30th, 2023 in May 2023, axonemes, bundle, Chlamydomonas Reinhardtii, crowding agents, Microtubules
Detection of cyberbullying comments in tweets
XGBoost classifier can be used for cyberbullying detection on social media platforms like Twitter.
Posted by John Lee on Tuesday, May 30th, 2023 in May 2023, Cyberbullying, Machine learning, NLP, Vader Sentiment, XGBoost
Strong signatures of toponium via \(t\bar{t}\) decay in ATLAS
Dileptonically decaying top quarks from simulated toponium events are analysed and distributions of the sum of the transverse momenta are computed.
Posted by John Lee on Tuesday, May 30th, 2023 in May 2023, Dileptonic Decay of Top Quarks, Distribution of Transverse Momenta, Top Quarks, Toponium
Biomedical Devices, Remote Health Monitoring, and Their Impact
Biomedical devices can be used in remote healthcare, which can improve health experiences for various populations.
Posted by John Lee on Tuesday, May 30th, 2023 in May 2023, Biomedical devices, personalized medicine, remote health care, Telehealth
Review: Outstanding hazards of radionuclides from the West Lake Landfill
The lasting effects of radionuclides detected at residences and the hazards they contain.
Posted by John Lee on Tuesday, May 30th, 2023 in May 2023, Radioactive waste, Radionuclides, West Lake Landfill
Pregnancy and COVID-19: The impact on prenatal care and maternal outcomes
Evaluation of five levels of prenatal care utilization and maternal outcomes to compare differences in probability from the pre-COVID-19 period to pandemic periods.
Posted by John Lee on Tuesday, May 30th, 2023 in May 2023, COVID-19, Maternal Outcomes, Pregnancy, Prenatal Care
Identifying the Status of Telehealth for Cancer Patients in the Rural Northeastern United States
Surveyed oncologists in the rural northeastern United States allow for the prediction of future improvements for cancer care-related telehealth.
Posted by John Lee on Tuesday, May 30th, 2023 in May 2023, Access, cancer, Rural, Telehealth
Employing Machine Learning Techniques and Frameworks to Aid with Automotive Design
Modifying existing machine learning techniques and architectures to design a new generative model tailored to automotive design.
Posted by John Lee on Tuesday, May 30th, 2023 in May 2023, Automotive Design, Generative Models, Machine learning, Stack-Gan
Automating Human Sleep Staging Analysis from Polsomnographic Recordings with a Discrete Hidden Markov Predictive Model
This research project utilized a Discrete Hidden Markov Model to design an algorithm capable of completing human sleep staging analy-sis without the need for a human technician.
Posted by John Lee on Tuesday, May 30th, 2023 in May 2023, Hidden Markov model, polysomnography., sleep staging analysis
Effects of artificial algal-bacterial symbioses (E. Coli K-12, C. Fruendii, & E. Coli MC4100) on microbial hydrogen production
A look into how various bacteria species affect the rate of H2 production in Chlamydomonas algae as a step forward to a hydrogen economy.
Posted by John Lee on Tuesday, May 30th, 2023 in May 2023, biochemistry, environmental, hydrogen, microbes, Sustainability
Physiologically Efficacious Recycled Synthetic Polymers for Ro-bust Prosthesis Production in Low-income Countries
Through tensile testing and computational analysis, effective synthetic polymers for robust prostheses production are developed.
Posted by John Lee on Tuesday, May 30th, 2023 in May 2023, Assistive Technology, Biomedical Engineering, Prosthesis Production, Synthetic Polymers
Confirming the Suitability of Unnatural Amino Acids as Labels to Monitor Structural Changes in Amyloid-Beta(40) with Two-Dimensional Infrared Spectroscopy
This study uses azidohomoalanine as an unnatural amino acid label to establish its usability as such when monitoring the pathways between monomer and oligomer of Amyloid-Beta (40).
Posted by John Lee on Tuesday, May 30th, 2023 in May 2023, Amyloid-Beta, label, oligomer
Evaluating the Affinity of Tumor-Specific and Self-Specific CD8+ T Cells in a Liver Cancer Mouse Model
Tumor-specific and self-specific CD8+ T cells have a difference in their affinity to their antigen.
Posted by John Lee on Tuesday, May 30th, 2023 in May 2023, cancer, CD8+, Immunology
Study on Optimal SARS-CoV-2 Containment Strategies Using Ex-tended SEIR Model
Mathematical modeling and simulation to study epidemic disease spreading and containment considering vaccine and testing impact.
Posted by John Lee on Tuesday, May 30th, 2023 in May 2023, COVID, Epidemic Disease Modeling, SARS-CoV-2, Virus Containment
Crossing the blood-brain barrier: recent advances in nanoparticle strategies for drug delivery to the CNS
This paper summarizes the latest advances in the clinical translation of nanoparticle-based systems for blood-brain barrier crossing.
Posted by John Lee on Tuesday, May 30th, 2023 in May 2023, Blood Brain Barrier, clinical trials, drug delivery, Nanoparticles
Evaluating Cell Culture Systems for Engulfment Receptor Function: Jedi-1 in BV2 and HeLa Cells
Jedi-1 is not expressed endogenously by BV2 cells; transfection of HeLa cells with Jedi-1 induces engulfment of apoptotic neural cells.
Posted by John Lee on Tuesday, May 30th, 2023 in May 2023, HeLa, Jedi-1, microglia, Neuroscience
Investigating the Correlation Between Phytoncide and Gut Bacteria to Maintain Strong Immunity and Brain Health of Astronauts
The metabolites of lung cells exposed to phytoncide are used to treat human immune and brain cells to test for the ability of phytoncide to improve immune and brain health in astronauts aboard spacecraft.
Posted by John Lee on Tuesday, May 30th, 2023 in May 2023, Immunity, Microbiome, Phytoncide, Spacecraft
Survival of Tribolium confusum when co-infected with gregarine parasite at different life stages and Bacillus thuringiensis infection
Flour Beetles were exposed to two immune threats to assess how their fitness would change due to the life stage and dosage of the threat.
Posted by John Lee on Tuesday, May 30th, 2023 in May 2023, Bacillus thuringiensis infection, co-infection, parasitic exposure, Tribolium confusum
A Review and Comparative Analysis of Breast Cancer Segmentation Using U-Net and Its Variants
This study evaluates U-net and its attention-based variants for the breast cancer segmentation using WSI of Data Science Bowl 2018.
Posted by John Lee on Tuesday, May 30th, 2023 in May 2023, breast cancer, Deep learning, Histopathological images
Tracking Provenance of Glacial Sediments in Ong Valley, Antarctica
Comparing sections of till in Ong Valley to track the past movement of the Argosy glacier.
Posted by John Lee on Tuesday, May 30th, 2023 in May 2023, Antarctica, detrital zircon, Ong Valley
Recalibration and Spatial Recall in an Immersive Virtual Environment
A study of the effects of age and gender of spatial memory in a virtual environment.
Posted by John Lee on Tuesday, May 30th, 2023 in May 2023, Locomotion, Spatial Memory, Virtual reality
Automated diagnosis of 7 retinal diseases with convolutional neural networks in a dataset of 2,234 eye images
Automated diagnosis of retinal disease with convolutional neural networks achieving a validation F1-score accuracy of 96% and 95% on cataracts and pathological myopia respectively.
Posted by John Lee on Tuesday, May 30th, 2023 in May 2023, convolutional neural networks, healthcare, Machine learning
Ligand Dose Response for Different Affinity Synthetic Receptors on an Engineered Biomaterial Surface
Utilizing the synNotch synthetic receptor platform, we tested two different affinity GFP responsive receptors to understand their activa-tion thresholds for purpose of developing a platform for regenerative engineering.
Posted by John Lee on Tuesday, May 30th, 2023 in May 2023, Biomaterials, Pluripotent Stem Cells, Regenerative Engineering, Synthetic Receptors, Tissue Engineering
Devising a Method for Physically Generating Phase Aberration in Ultrasounds Using Phantoms
Creating artificial tissues to physically generate phase aberration in ultrasounds
Posted by John Lee on Tuesday, May 30th, 2023 in May 2023, Aberration, Phantom, Phase, Ultrasound
Biological Sex and Socioeconomic Status Influences on Behavioral and Neural Markers of Speech Processing in Preschool Children in Brazil
The distinctive impact of socioeconomic status on auditory processing and limited effect on behavioral testing while biological sex shows no overall variance in either measure.
Posted by John Lee on Tuesday, May 30th, 2023 in May 2023, Biological Sex, Cortical Auditory Event-Related Potential (CAEP), P1-N1-P2 complex, Socioeconomic Status (SES)
Determining the value of a cricket player: Does bowling ability have a greater effect on the rating of a cricket player than batting ability?
Using machine learning to analyze and compare how different variables affect the rating of a cricket player
Posted by John Lee on Tuesday, May 30th, 2023 in May 2023, cricket, Machine learning, regression, Sports analytics
A ONE-DIMENSIONAL PROOF OF THE HÖLDER INEQUALITY USING THE HEAT EQUATION
This paper displays an alternative approach to proving the Holder Inequality using supersolutions of the Heat Equation for a one-dimensional case.
Posted by John Lee on Tuesday, May 30th, 2023 in May 2023, Heat Equation, Hölder, Inequality
Defining Evaluation Metrics for Medical Imaging Datasets
Define metrics to evaluate medical imaging datasets to improve the accuracy and reliability of model results.
Posted by John Lee on Tuesday, May 30th, 2023 in May 2023, Computer Vision, Dataset Reliability, Medical Imaging Datasets
Defining the Immunogenomics of Allopurinol-Induced SJS/TEN
This study aims to validate the involvement of a known HLA risk allele associated with ALP-SJS/TEN as well as to identify other novel HLA alleles or immune factors associated with disease pathogenesis.
Posted by John Lee on Tuesday, May 30th, 2023 in May 2023, Adverse Drug Reaction (ADR), allopurinol (ALP), cytotoxic CD8+ T-cell, HLA Class I alleles, keratinocytes, Severe Cutaneous Adverse Reaction (SCAR), Stevens-Johnson Syndrome / Toxic Epidermal Necrolysis (SJS/TEN), T cell Receptor (TCR)
Creating a Physics and Computational Thinking Curriculum using a 3D Virtual Learning Environment
A curriculum taught through a 3D virtual learning environment was designed to help high school students learn and improve their self-efficacy in physics while developing their computational thinking skills.
Posted by John Lee on Tuesday, May 30th, 2023 in May 2023, 3D virtual learning environment, Computational thinking, Physics
Electrodialytic Crystallization for Non-Evaporative Water and Salt Recovery
Electrodialytic Crystallization of saltwater brine for zero liquid discharge.
Posted by John Lee on Tuesday, May 30th, 2023 in May 2023, Brine, Crystallization, Electrodialysis, Salt
Utilizing Predictive Models to Detect Parkinson’s Disease Via Fractal Scaling
Using Machine Learning to solve Degenerative Diseases
Posted by John Lee on Tuesday, May 30th, 2023 in May 2023, Early Diagnosis, Fractal Scaling, Machine learning, Parkinson’s disease, Voice Detection
An Assessment of Diel Patterns in the East Fork Creek, Franklin, TN
A characterization of the health of the East Fork Creek using diel cycles and stream metabolism analysis.
Posted by John Lee on Tuesday, May 30th, 2023 in May 2023, Bayesian analysis, Stream metabolism, Water Quality
Breaking Down the Development of Children’s Ordinality Understanding
This paper analyzes the association of various early number skills with the development of numeral ordinality knowledge.
Posted by John Lee on Tuesday, May 30th, 2023 in May 2023, Children, education, Number, Ordinality
Investigating the Roles of TRP Channels in Nociception and Analgesic Applications
This literature review assesses the role of nociceptive TRP channels, wild-type or mutant, and how modulations of various TRP channels impact physiological roles in pain sensation.
Posted by John Lee on Tuesday, May 30th, 2023 in May 2023, Analgesics, Nociception, TRP Channels, TRP Mutations
The Adverse Effects of Cocaine on the Adolescent Brain
Researches have observed the drastic consequences of cocaine to be greater when used during adolescence, as it stunts the development and growth of the brain.
Posted by John Lee on Tuesday, May 30th, 2023 in May 2023, Adolescent, Brain Development, Cocaine, Gray Matter
Comparative Analysis of Prostate Cancer Detection Methods in Emulating Ground Truth Accuracy
This study evaluates the performance of prostate cancer detection algorithms and architectures for optimal clinical application.
Posted by John Lee on Tuesday, May 30th, 2023 in May 2023, Deep learning, MRI images, prostate cancer
Developing cheaper and safer non-weather-based AI models for microgrid demand and supply forecasting in rural areas
This study examines how to make microgrid scheduling using AI forecasting methods simpler, cheaper, and safer using alternative sources of data other than weather data, in order to accelerate the spread of solar power in rural areas.
Posted by John Lee on Tuesday, May 30th, 2023 in May 2023, Artificial Intelligence, Machine learning, microgrid forecasting, renewable energy, rural areas
Providing Recommendations on Combating Climate Change Through Data Driven Analysis
This study applies data science techniques in order to recommend further action toward combating climate change.
Posted by John Lee on Friday, May 19th, 2023 in May 2023, climate change, Machine learning, Sustainability